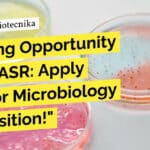
"Exciting Opportunity at JNCASR: Apply Now for Microbiology JRF Position!"

Home Search
biology - search results
If you're not happy with the results, please do another search
Exciting Research Opportunity: Join AICCRS Life Sciences JRF Job and Revolutionize STEM Cell Biology!
AICCRS Life Sciences JRF Job - Applications Invited
Name of Posts: Junior Research Fellow (JRF)
Number of posts: 01
Research Project: "Biogenic Carbon Quantum Dots: A Neoteric...
NIAB Hiring! Life Sciences, Biotech, Biochem & Microbiology SRF Post, Apply Online
NIAB Hiring! Life Sciences, Biotech, Biochem & Microbiology SRF Post, Apply Online
Advt. No. 03/2024
Applications are invited from suitable candidates for filling up the following...
Attention Microbiology Enthusiasts! Exciting Research Position Available at MAHE Manipal – Apply Now!
MAHE Manipal Microbiology Research Position Available - Applications Invited
Research Position
Manipal Academy of Higher Education (MAHE), Manipal invites applications from eligible candidates for the following...
Sun Pharma Biotech Manager IP – Biotech, Biochem & Microbiology Apply
Sun Pharma Biotech Manager IP - Biotech, Biochem & Microbiology Apply
Manager IP- Prosecution (Biotech) Job Posting
Job Summary:
Management of the branded portfolio ( Biologics) from...
Want to be a Protein Biology Rockstar? Apply Now for this Scientist I Position...
Thermo Fisher Protein Biology Scientist Job - Apply Online
Job Posting: Scientist I, Protein Biology
Job Location: India, Bangalore
About the Company:
Thermo Fisher Scientific Inc. is the...
CSIR-IICT Hiring! Biotech & Microbiology Attend Walk-In, MSc & BTech & Non-NET Eligible
CSIR-IICT MSc & BTech Jobs - Biotech & Microbiology Attend Walk-In
CSIR – INDIAN INSTITUTE OF CHEMICAL TECHNOLOGY
Council of Scientific & Industrial Research
Hyderabad – 500...
Get Hired as a Senior Research Fellow in Indore – ICAR-IISR SRF Recruitment for...
ICAR-IISR SRF Recruitment - Life Sciences & Microbiology Attend Walk-In
ICAR-Indian Institute of Soybean Research
(ISO 9001:2015 Certified Organization)
Khandwa Road, Indore 452 001 (M.P.) India
Interview Notice
Applications...
DRDO-DIHAR Hiring 10+ Govt JRFs in Biotech, Biochem, Immunology, Microbiology & Zoology! Apply Now!
DRDO-DIHAR Govt JRF Jobs For Biotech, Biochem, Immunology, Microbiology & Zoology
DEFENCE INSTITUTE OF HIGH ALTITUDE RESEARCH (DIHAR)
DEFENCE RESEARCH & DEVELOPMENT ORGANISATION (DRDO) WALK-IN INTERVIEW...
Beam Suntory QA Jobs – Biotech, Biochem, Microbiology & Food Tech Apply
Beam Suntory QA Jobs - Biotech, Biochem, Microbiology & Food Tech Apply
Executive QA
Date: Jan 24, 2024
Location: Hyderabad, TG, IN
Company: Beam Suntory
Beam Suntory is a world leader in...
Syngene Hiring! Biotech, Biochem & Microbiology With 6 Months Exp Apply Online
Syngene Hiring! Biotech, Biochem & Microbiology With 6 Months Exp Apply Online
Designation: Executive - QA
Requisition ID: 55473
Job Location: Bangalore
Department: Quality Assurance - GLP
About Syngene
Incorporated...
Food Safety Auditor Role at Diversey – BTech & MSc Food Science, Microbiology Apply...
Food Safety Auditor Role at Diversey - Apply Now!
Food Safety Auditor Role at Diversey
Location: Mumbai
Reporting to: Head Knowledge Services - India Subcontinent
Department: Marketing
Key Responsibilities:
...
Freshers BSc & MSc Job For Biotech & Microbiology – Apply For Lab Tech...
Fresher Biotech Lab Tech Jobs - BSc & MSc Microbiology Also Apply Online
About Gruner Renewable Energy
Gruner Renewable Energy is a leading company in the...
MACS-ARI Pune Scientist Job With Up To Rs. 1.77 Lakh pm Pay – Biotech...
MACS-ARI Pune Scientist Job With Up To Rs. 1.77 Lakh pm Pay - Biotech & Microbiology Apply Online
MACS-ARI Pune Scientist Job With Up To...
BSc Microbiology Vacancy at Cipla – Apply Online
Microbiology BSc Job Cipla - Apply Online For Team Member Role
Junior Team Member - Microbiology
Requisition ID: 79917
Company: Cipla
Employment Type: Permanent
Department: Quality
Job Purpose:
Execute analysis of...
Exciting Opportunity at JNCASR: Apply Now for Microbiology & Biochemistry JRF Position!
JNCASR Microbiology JRF Job Posting - Biochem Apply Online
Advt. No. CPMU/INST-EMR/29/23-24-Junior Research Fellow
Applications are invited for a temporary position of Junior Research Fellow ...